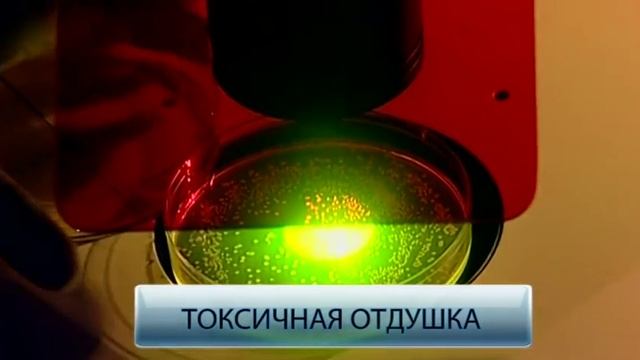
Cамый безопасный освежитель для авто! смотреть онлайн

Автор / Канал: Строительные Вдохновения Страница 22

Сделал корыто поросятам! Больше не будут есть с земли! #XATASKRAU

Карельская северная сосна Кело

Индукционный нагрев ТВЧ. Закалка шестерни

Венский стул женскими руками. Как обновить старый стул.

Экстрактор инструмент токарный

Bayer Luna Experience fungicide | Fluopyram + Tebuconazole | Luna | Systemic Fungicide

Щербинка. ЖК. Прима шкаф-купе с фасадами из кож зама и лдсп

РАСПАКОВКА REMS Амиго 2 Электрический резьбонарезной клупп с быстросменными головками

Гирлянда из цветной бумаги

Перегородка из газосиликатных блоков

Гамак палатка Stalker ekstrim гамак плюс тент установка тента Putnik

ОТРЕЗНОЙ СТАНОК. pendulum cutting machine

Крым. Люди волнуются. Отжим Верхнесадовского источника. Севастополь. Верхнесадовое.

Персик "Флеминг Фьюри ПФ Лаки 13".

Продлеваем плодоношение огурцов и увеличиваем урожай. Лучшие сорта огурцов для выращивания в теплиц

Укладка плитка на ванной комнате от А до Я
![ТОП-3 Лучших бюджетных игровых наушников до 100$ ? [РЕЙТИНГ] смотреть онлайн ТОП-3 Лучших бюджетных игровых наушников до 100$ ? [РЕЙТИНГ] смотреть онлайн](https://pic.rtbcdn.ru/video/c7/05/c705949e6812e0580d4fafd59c6db93d.jpg)
ТОП-3 Лучших бюджетных игровых наушников до 100$ ? [РЕЙТИНГ]

Пашем огород Крот Ом.

Фрезеровка акрила на станке с ЧПУ/ фрезеровка оргстекла

Пеноплекс(пенополистирол) и мышь

Монтаж светильника. Как повесить светильник своими силами.

Айва превосходная Оранж Трэйл. Краткий обзор, описание характеристик, где купить саженцы
Cамый безопасный освежитель для авто!

Для Чего Нужен Эксцентрик
За каждым успешным каналом стоит личность, идея и сотни часов кропотливого труда. Если вы здесь, значит, автор «Строительные Вдохновения» уже сумел зацепить ваше внимание своим уникальным стилем или подачей. А мы на RUVIDEO позаботились о том, чтобы вы могли изучить весь архив его работ в максимально комфортных условиях — без лишней суеты и преград.
Почему за работами канала «Строительные Вдохновения» так интересно наблюдать? Всё просто: это честный контент, который находит отклик в сердцах зрителей. На нашем ресурсе вы можете смотреть онлайн все видео любимого автора бесплатно и в хорошем качестве. Нам важно, чтобы вы видели каждую деталь и слышали каждый нюанс, поэтому мы используем только стабильные плееры из открытых источников Rutube.
Следите за новинками канала, пересматривайте старые шедевры и открывайте для себя новые грани творчества «Строительные Вдохновения». Мы постоянно обновляем ленту, чтобы у вас под рукой всегда были самые свежие выпуски. Никаких сложных регистраций — только вы и творчество, которое вдохновляет. Приятного вам путешествия по миру авторского контента на RUVIDEO!
Видео взято из открытых источников Rutube. Если вы правообладатель, обратитесь к первоисточнику.